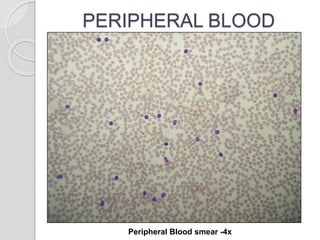
PERIPHERAL BLOOD
Peripheral Blood smear -4x
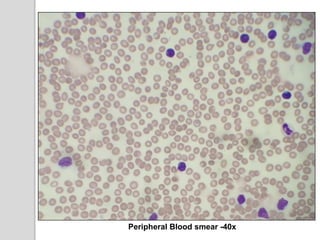
Peripheral Blood smear -40x
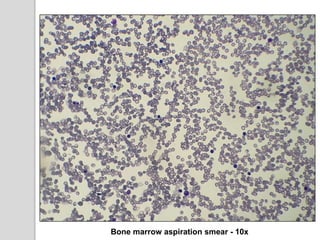
Bone marrow aspiration smear - 10x
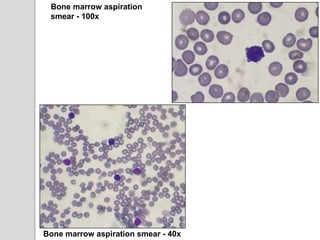
Bone marrow aspiration
smear - 100x
Bone marrow aspiration smear - 40x

This document presents a case study of a 42-year-old male who presented with abdominal pain and was found to have a markedly elevated lymphocyte count on blood tests. Further testing revealed the lymphocytes to be abnormal in morphology. Bone marrow biopsies and additional testing led to a diagnosis of T-cell prolymphocytic leukemia (T-PLL), a rare and aggressive form of T-cell lymphoma. The document discusses the clinical features, distinguishing characteristics from other lymphomas, molecular genetics, disease progression, and poor prognosis of T-PLL.